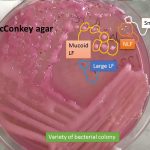
MacConkey with various bacterial colonies
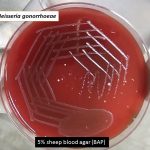
Neisseria on blood agar

Collection Group: Clinical Bacteriology
Various Bacterial Colony on MacConkey Agar: Introduction and Its Details
MacConkey agar with various bacterial colonies MacConkey agar having the...
MacConkey agar with various bacterial colonies MacConkey agar having the...
Neisseria gonorrhoeae in Urethral Discharge: Introduction, Procedure and Result-Interpretation
 Urethral discharge in Gram stain Urethral discharge in Gram stain...
Urethral discharge in Gram stain Urethral discharge in Gram stain...
Neisseria on Blood Agar: Introduction, Culture characteristics, Pathogenecity, Laboratory Diagnosis and Treatment
Neisseria gonorrhoeae Introduction Neisseria gonorrhoeae, also called Gonococcus which causes...
Neisseria gonorrhoeae Introduction Neisseria gonorrhoeae, also called Gonococcus which causes...
